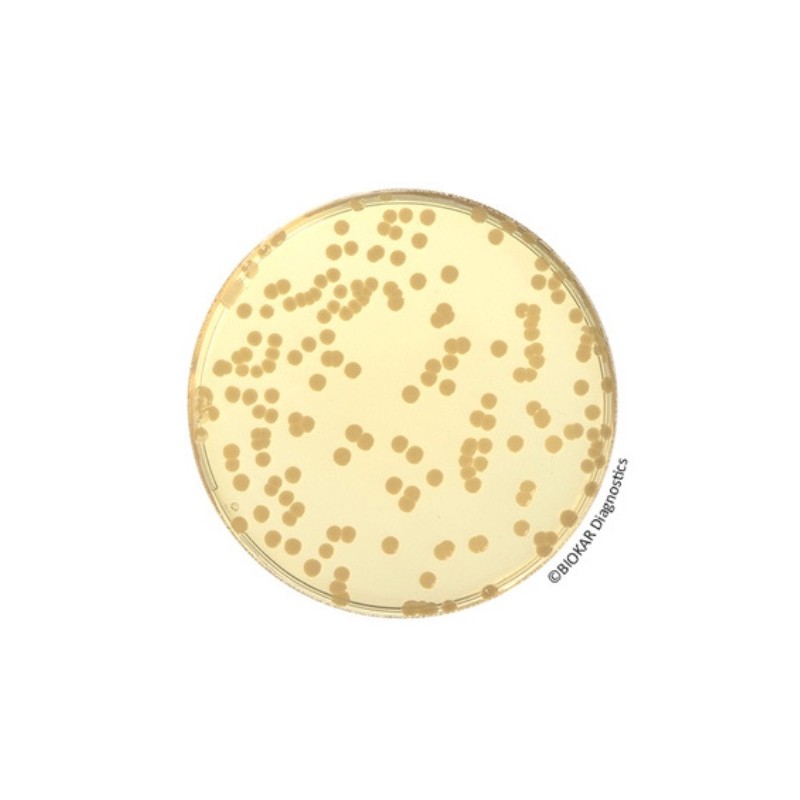
Gélose pour dénombrement (PCA) (PAE)

- +Produits
- +Consommables de laboratoire
- +Équipement de laboratoire
- +Équipement pour la microbiologie
- +Milieux de Culture - réactifs et trousses de performance
- +Solutions de sécurité alimentaire Neogen®
- +Systèmes de surveillance des températures et de l'humidité
- +Tests d'allergènes
- +Tests environnementaux
- +Services
- SUPPORT
- Nouvelles
- +À propos de nous
- Contact

Gélose pour dénombrement (PCA) (PAE)
La gélose glucosée à l’extrait de levure, appelée par les Anglo-Saxons “Plate Count Agar” ou PCA, est utilisée en bactériologie alimentaire pour le dénombrement des bactéries aérobies dans les produits alimentaires, les produits d’alimentation animale et les échantillons de l’environnement.
Elle est aussi utilisée pour le dénombrement des microorganismes psychrotrophes.
La formule-type répond à la composition définie dans les normes NF EN ISO 4833-1 et 2, NF ISO 17410, XP V08- 034 ; T90-425 et ISO 14461-1.
Disponible en milieu prêt-à-l’emploi : 20 ou 120 boîtes de Ø 90 mm
Ou en milieu prêt-à-liquéfier :
10 flacons de 100 ml
10 flacons de 200 ml
Aussi disponible en milieu déshydraté 500g ou 5Kg (BK144HA ou BK144GC).
En vertu des exigences réglementaires, un permis de l'USDA (VS 16-3) est obligatoire pour les expéditions du Canada vers les États-Unis en raison de l'inclusion de peptone, un sous-produit animal.
Les substances nutritives apportées par la Tryptone, les facteurs vitaminiques de l’extrait de levure et le glucose (source énergétique) favorisent la croissance de la plupart des bactéries à dénombrer.
En bactériologie laitière, il est recommandé d’ajouter 1 g de lait écrémé en poudre par litre de milieu reconstitué (gélose pour dénombrement au lait écrémé ; BK161HA ou BM086).
Produits connexes